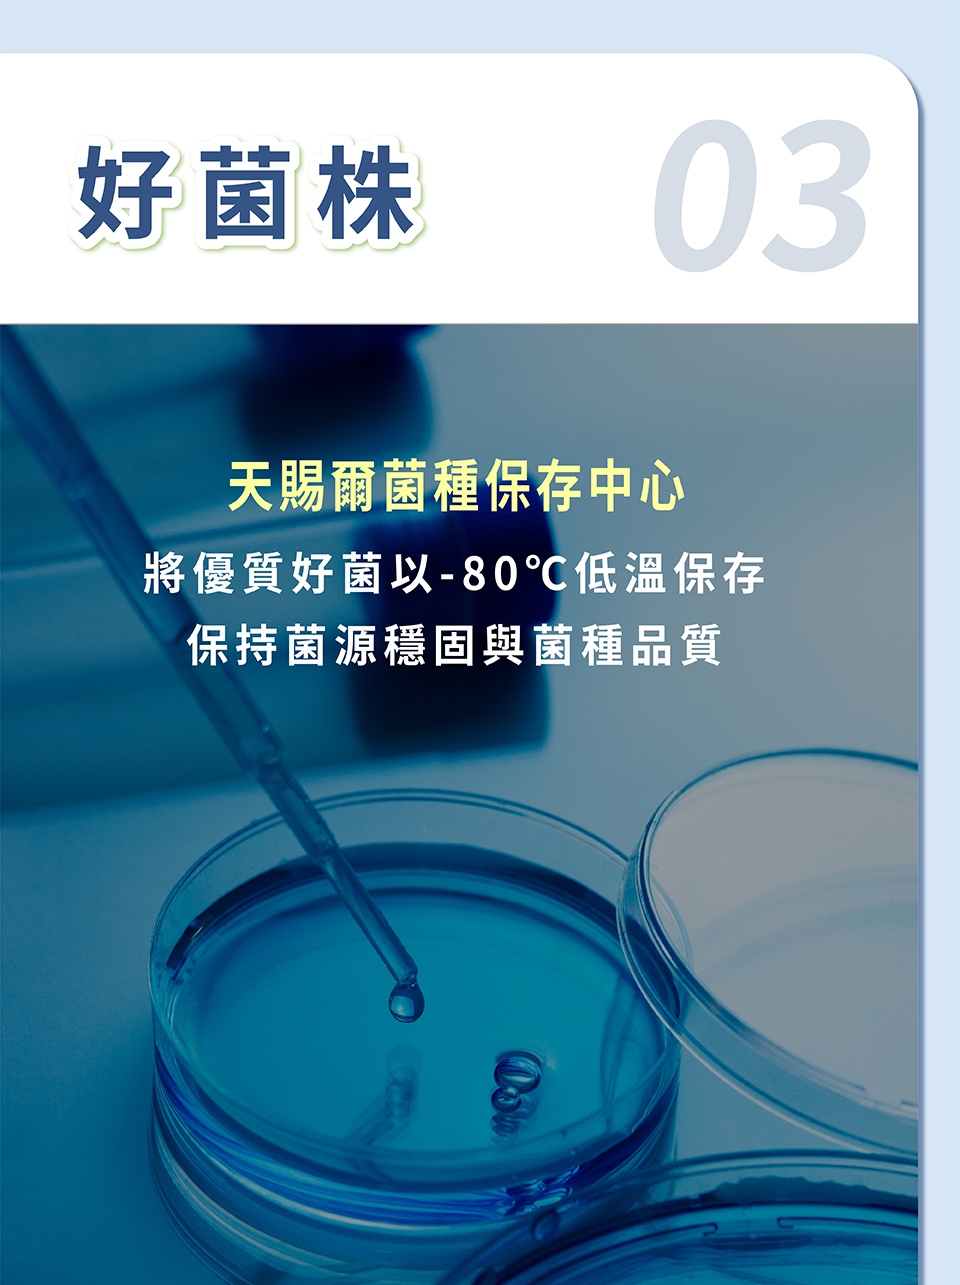

商品詳細介紹

體驗說明
不可體驗
使用方法說明
■用途:可改善胃腸功能,品質有保證,並能促進體內環保、使排便順暢、幫助消化、促進新陳代謝等。
■食用方法:幼童,建議一天1包,分2-3次吃,可加在牛奶或開水、果汁一起食用(食用溫度需低於45℃)。
青少年及成人:一天1~3包。
■食用方法:幼童,建議一天1包,分2-3次吃,可加在牛奶或開水、果汁一起食用(食用溫度需低於45℃)。
青少年及成人:一天1~3包。
注意事項
1.體內環保從腸道開始,本產品為日常保健之健康食品,請遵照建議食用量使用
2.請洽詢醫師或營養師有關食用本品之意見
3.均衡的飲食及適當的運動為身體健康之基礎
4.本產品含有乳糖,乳糖不耐症者請洽詢醫師或營養師有關食用本品之意見
5.本產品為保持原有風味及活菌數,不做二次加工,致劑型顆粒大小不一,口感或有差異
■保存方式:請置於陰涼乾燥通風處,避免高溫及日光直接照射。
■保存期限:1年
■生 產 地:台灣
2.請洽詢醫師或營養師有關食用本品之意見
3.均衡的飲食及適當的運動為身體健康之基礎
4.本產品含有乳糖,乳糖不耐症者請洽詢醫師或營養師有關食用本品之意見
5.本產品為保持原有風味及活菌數,不做二次加工,致劑型顆粒大小不一,口感或有差異
■保存方式:請置於陰涼乾燥通風處,避免高溫及日光直接照射。
■保存期限:1年
■生 產 地:台灣